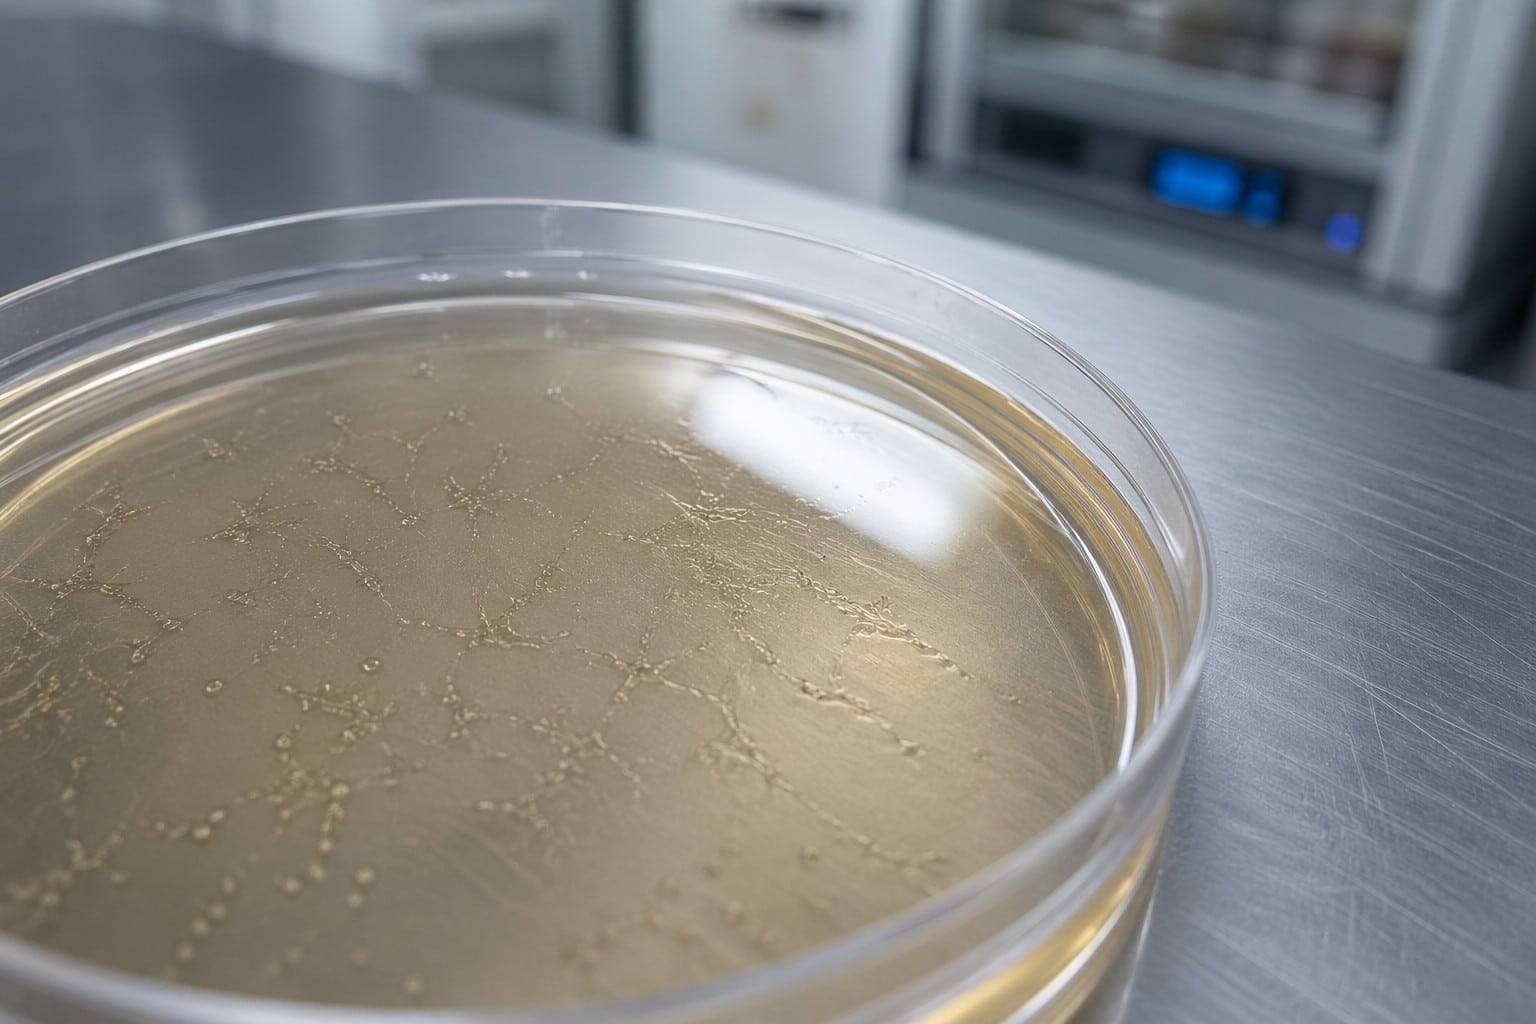

Una startup dello Utah dice di aver fatto nascere spermatozoi adulti partendo da cellule staminali, in una piastra di laboratorio. L’azienda si chiama Paterna Biosciences (il nome dice tutto), è nata dall’Università dello Utah con l’appoggio della Mayo Clinic, e sostiene di aver già usato quegli spermatozoi per creare embrioni umani di prova. Se regge, è la prima vera novità nel trattamento dell’infertilità maschile da trent’anni a questa parte, dall’arrivo della ICSI.
Il problema dell’infertilità maschile tocca più di un uomo su otto tra i 25 e i 49 anni solo negli Stati Uniti. In Italia interessa circa il 7% degli uomini e circa il 15% delle coppie. L’annuncio è arrivato su Wired in esclusiva: sulle riviste scientifiche, per ora, non c’è niente. Posso autorizzarmi allo scetticismo? Intanto vediamo un po’.
Cosa hanno fatto, esattamente
Il procedimento parte da una piccola biopsia testicolare, da cui si estraggono le cosiddette cellule staminali spermatogoniali: sono quelle che nel corpo, in condizioni normali, diventano spermatozoi. Il punto è che nel corpo lo fanno grazie a un microambiente complicatissimo, fatto di segnali ormonali, fattori di crescita, cellule di supporto. Ricrearlo in una piastra è da decenni il santo Graal della medicina riproduttiva, e ci hanno provato in tanti senza riuscirci.
Il cofondatore di Paterna, Alexander Pastuszak, urologo e professore all’Università dello Utah, racconta che il suo team ha preso la strada della modellistica computazionale: hanno mappato al computer i segnali molecolari necessari a ogni stadio della maturazione, poi hanno testato le combinazioni di fattori di crescita finché le cellule non hanno completato la meiosi e sviluppato la classica forma a testa e coda.
“Abbiamo capito le istruzioni necessarie per insegnare a queste staminali a diventare spermatozoi maturi e normali”, è la sintesi che ha dato a Wired.

Scheda studio
- Azienda: Paterna Biosciences (Salt Lake City, Utah)
- Fondatori: Alex Pastuszak, Jim Hotaling, Brad Cairns, Kyle Orwig
- Seed round: 6 milioni di dollari (ottobre 2024, guidato da SpringTide Ventures)
- Accelerator: Mayo Clinic/ASU MedTech (Disruption Award 2025), Tampa Bay Wave HealthTech|X 2025
- Costo previsto procedura: 5.000-12.000 $, non comprensivi della FIV (15.000-30.000 $ a ciclo)
- Pubblicazione peer-reviewed: nessuna, al 24 aprile 2026
- Annuncio: esclusiva Wired, 23 aprile 2026
Infertilità maschile e i dettagli che mancano
L’azienda dice di aver già fecondato ovuli e ottenuto embrioni “apparentemente sani”. La parola chiave è apparentemente: gli embrioni non sono stati impiantati, servivano solo come validazione preliminare della sicurezza. E qui sta il punto, che ribadisco: nulla di tutto questo è stato pubblicato su una rivista scientifica peer-reviewed. L’annuncio è un’esclusiva a un magazine, rilanciata dai comunicati stampa dell’azienda.
Non è un dettaglio da poco. Nel 2015 una startup francese, Kallistem, aveva fatto più o meno la stessa cosa: conferenza stampa, promessa di spermatozoi umani maturati in laboratorio, entusiasmo. I risultati furono poi contestati da esperti esterni e la storia si sgonfiò. Un altro annuncio simile nel 2009 finì ritirato da una rivista per accuse di plagio. Il campo ha una memoria, e non è tenera.
Paterna ha però un curriculum che negli altri casi mancava: lo sponsorship della Mayo Clinic, un primo finanziamento da 6 milioni, fondatori accademici che pubblicano da anni. Il che non sostituisce la peer review, ma (spero) la rende più probabile a breve.
Il pezzo che il comunicato stampa non racconta
Ammesso che regga tutto, scusate se faccio sempre il grillo parlante, resta la questione importante di chi potrà permetterselo. Paterna dichiara 5.000-12.000 dollari per la procedura: sembrano in linea, forse anche meno dei soldi necessari a un ciclo FIV tradizionale, ma qui l’errore è pensare che uno sostituisca l’altro. Sono costi che si sommano: servono comunque la FIV, l’ICSI, tutto il resto. Chi deciderà davvero il costo reale di una procedura come quella di Paterna?
Per gli uomini con azoospermia non ostruttiva, che oggi non hanno nessuna opzione a parte una chirurgia invasiva che riesce solo nel 50% dei casi, una tecnica del genere sarebbe comunque un sollievo enorme. Se arriva. Se funziona davvero. Se qualcuno riesce a pagarsela.
L’idea di coltivare spermatozoi in laboratorio non è nuova, il traguardo viene annunciato ogni qualche anno, e come per il metodo Fertilo sul versante femminile, la distanza tra il comunicato stampa e la clinica vera si misura ancora in anni.
Per adesso, a Salt Lake City, ci sono spermatozoi che nuotano in una piastra. Cosa diventano, fuori da quella piastra, lo sapremo quando qualcuno ci farà leggere lo studio.